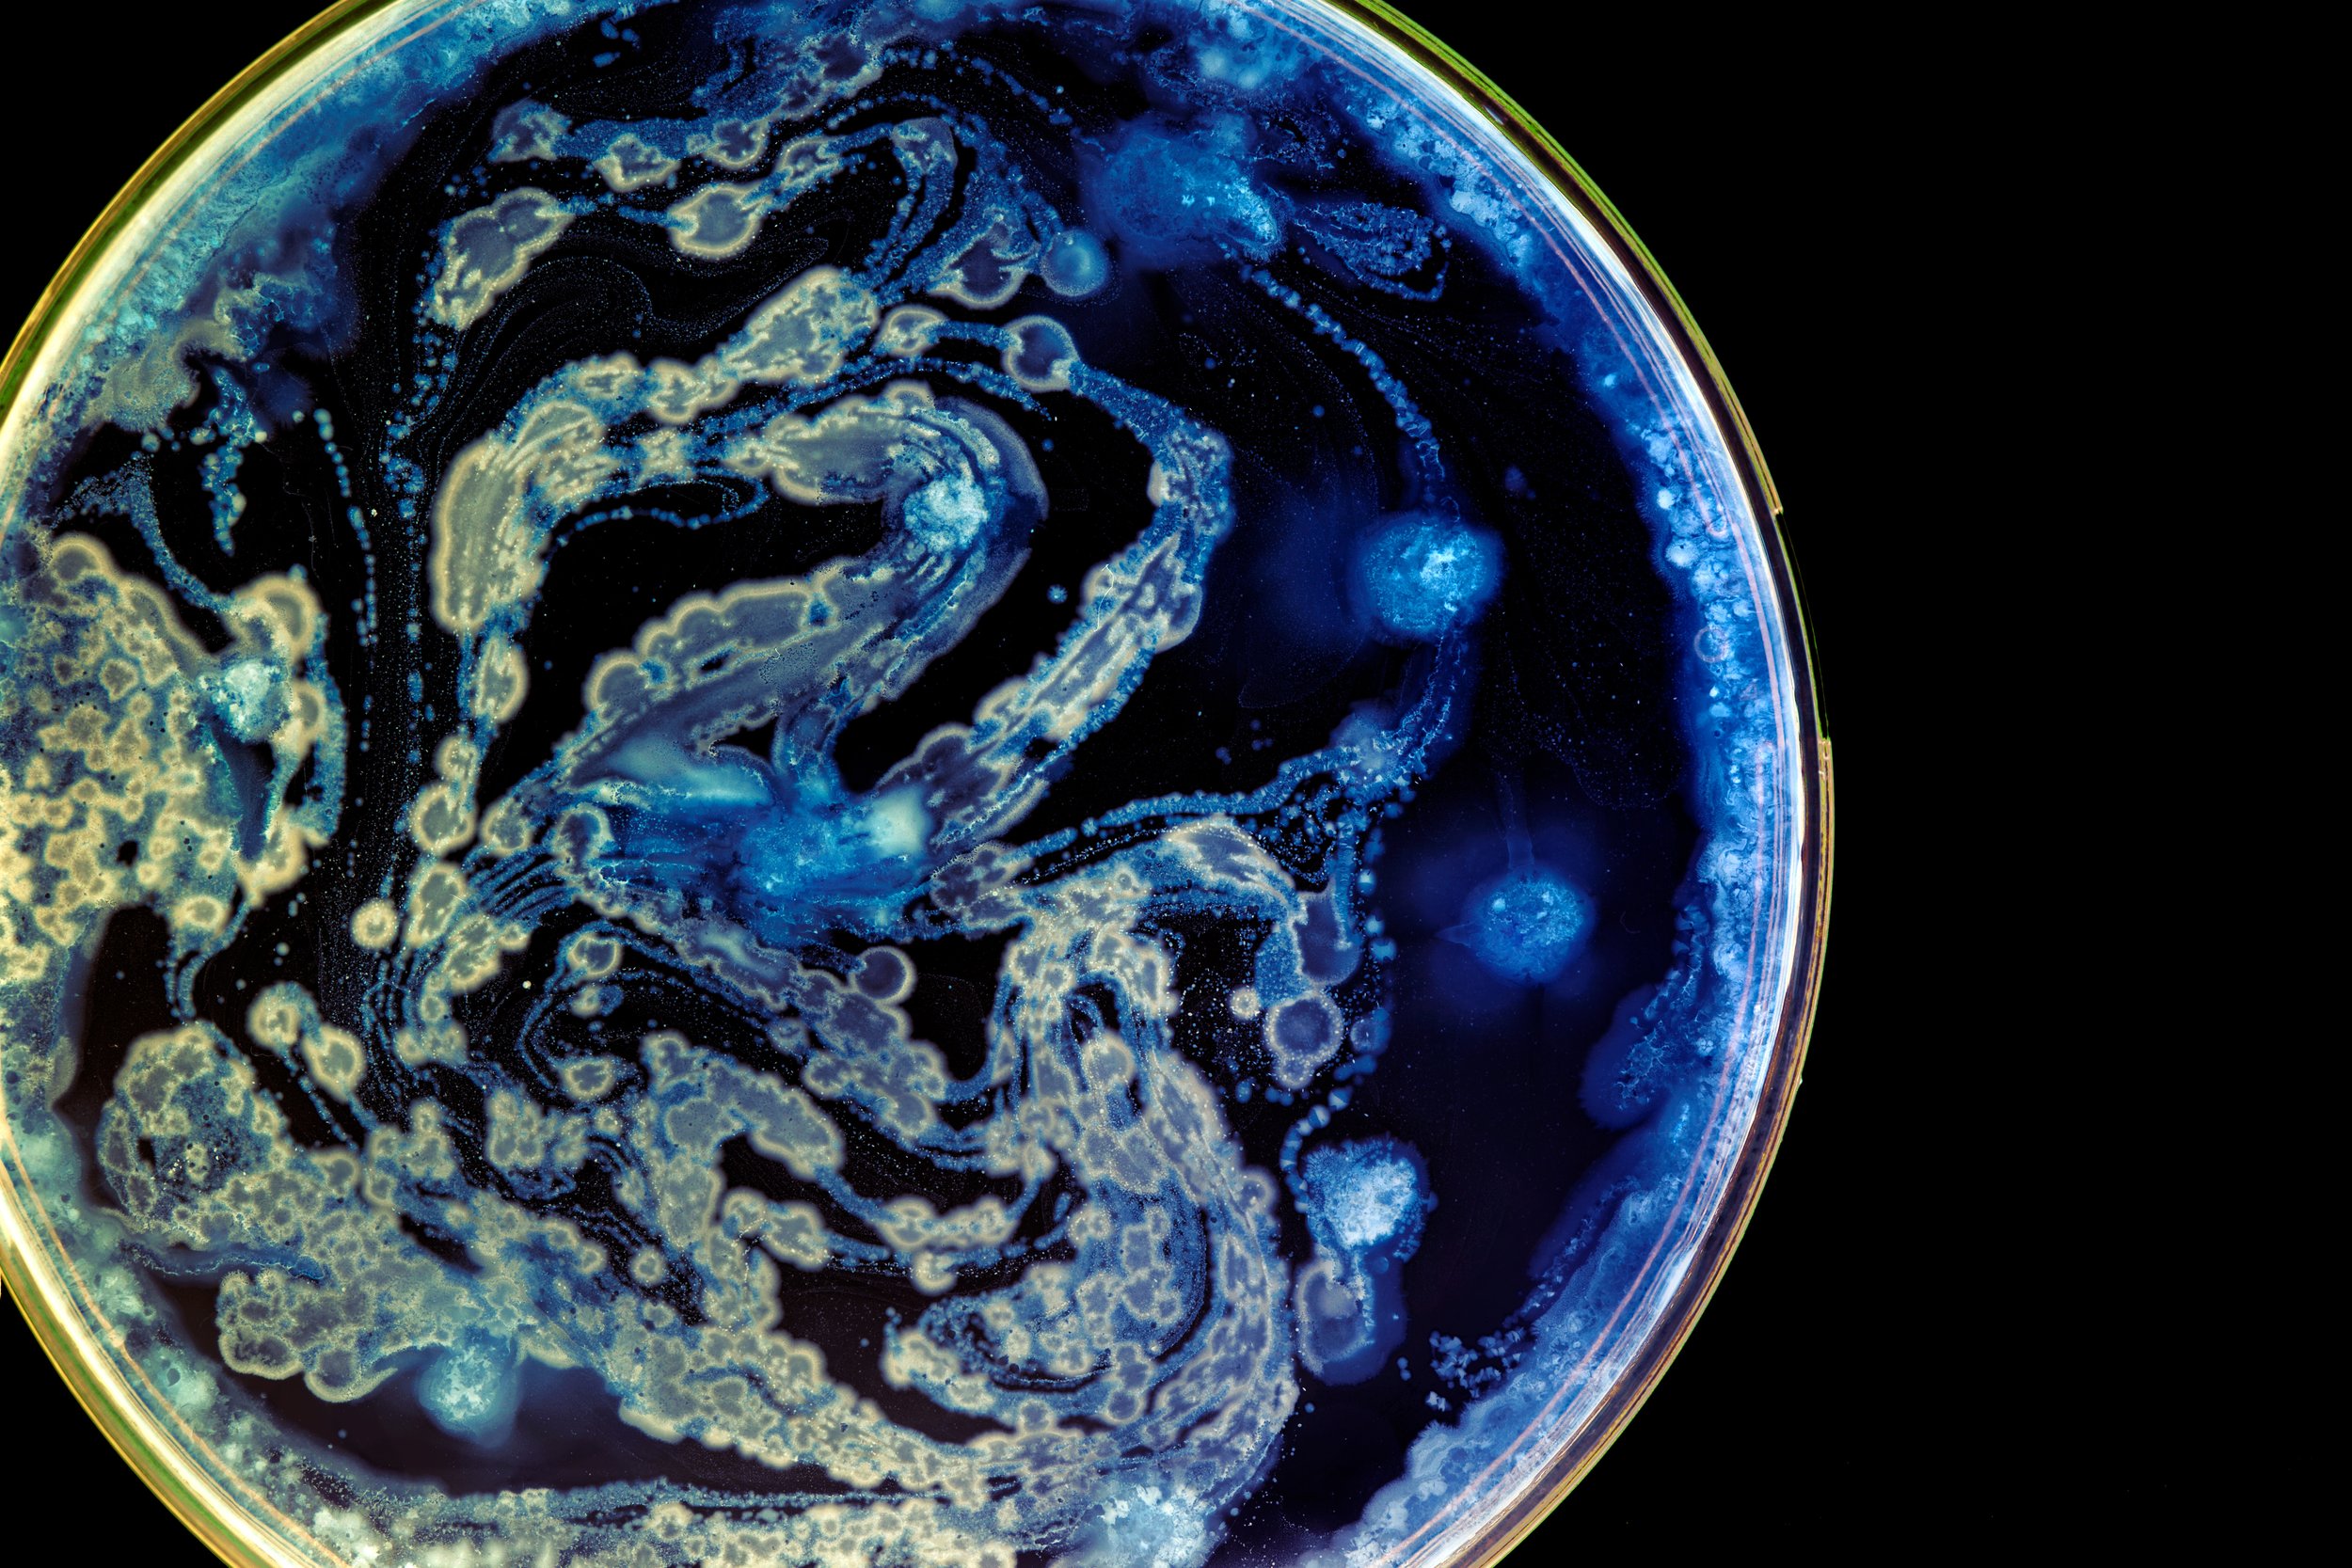
Close-up view of a petri dish with blue and yellow bacterial or fungal colonies developing in swirling and circular patterns.

We’re reinventing the chemistry of color with bio‑based pigments that drop into modern production and transform how dye is made. Indigo is our first focus — and only the beginning.
Ingredients Matter,
Even In Your Clothes
It’s a little known fact: the indigo blue that gives jeans their iconic look is highly polluting to the environment and made with toxic ingredients. Conventional indigo requires dangerous chemicals – like benzene, formaldehyde, and sodamide – and carbon-emitting petroleum to produce.
A Greener Blue
Can Help Save Earth
We’re making sustainable indigo blue for the denim industry so that your favorite piece of clothing can finally be planet-friendly, too. Biosynthetic indigo has five times less toxicity potential compared to chemical sources, and our dye is just as effective and easy for jeans makers to implement.
Color, Reimagined From the Source Instead of using toxic chemicals, we turn sugar into dye. Our team studies how color occurs in nature, then uses proprietary bioengineering to create microbes that mirror those natural pathways and convert sugar into vibrant pigment. It’s the only dye technology that’s both sustainable and fully compatible with existing manufacturing — a true one‑to‑one solution.
No Petroleum
Today, every kilogram of indigo produced uses 75x the amount of petroleum. Huue’s biotechnology doesn’t rely on fossil fuels of any kind, enabling a cleaner, greener blue.
Nothing Toxic
For the last century, indigo has been made with harsh substances like cyanide and formaldehyde. Our jeans are made without skin irritants or poisons.
Less Pollution
Dyeing is the dirtiest part of denim production. Our environmentally-friendly process can eliminate the need for water-polluting chemical reducing agents.
Meet the Team
-

Corinna Chen
CEO
-

Lance Kizer
CTO
-

Tammy Hsu
PRINCIPAL SCIENTIST &
CO-FOUNDER -

DK Ko
DIRECTOR
DSP -

Wayne Jones
PRINCIPAL SCIENTIST
FERMENTATION -

Abolfazl Aghanouri
PRINCIPAL SCIENTIST
TEXTILES
Our Investors
Join Us
Please visit our LinkedIn page for the latest information about opportunities to join our team.







